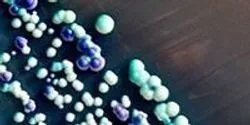

All by Johns Hopkins Medicine
Filter by
AllArticlesAudioEbooksEventsInfographicsNewsProductsSurveysDocumentsVideosVirtual EventsWebinars
Researchers discover a critical cellular “off” switch for the inflammatory immune response that causes asthma attacks
| 3 min read